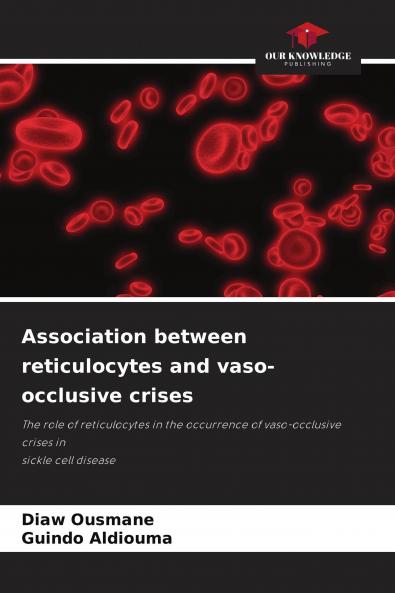
Association between reticulocytes and vaso-occlusive crises

English
Paperback
₹4195
(All inclusive*)
Delivery Options
Please enter pincode to check delivery time.
*COD & Shipping Charges may apply on certain items.
Review final details at checkout.
Looking to place a bulk order? SUBMIT DETAILS
Delivery Options
Please enter pincode to check delivery time.
*COD & Shipping Charges may apply on certain items.
Review final details at checkout.
About The Book
Description
Author
Sickle cell disease is a genetic disease characterized by the presence in red blood cells of an abnormal hemoglobin called hemoglobin S which is responsible for their sickling. This falciformation of the red blood cells obstructs the small vessels thus causing painful attacks called vaso-occlusive attacks of variable localization. This disease remains until proven otherwise the first genetic disease in the world; in Mali the prevalence of the disease is increasing day by day. With this work we wanted to detect a possible association between hyper-reticulocytosis and the occurrence of vaso-occlusive crises in sickle cell disease.We conducted a descriptive cross-sectional and analytical study of sickle cell patients followed at the CRLD during the period from March 15 to December 31 2010. Out of 956 registered patients 271 were included in the study. At the end of this study we found a statistically significant association between hyper-reticulocytosis and the occurrence of vaso-occlusive crises.
Details
ISBN 13
9786204124919
Publication Date
-29-09-2021
Pages
-68
Weight
-106 grams
Dimensions
-150x220x4.09 mm